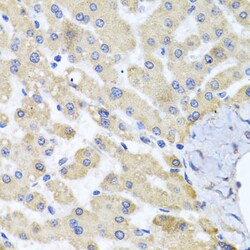
Invitrogen ABCB8 Polyclonal Antibody 100 &mu;L; Unconjugated:Antibodies,

Learn More
Invitrogen™ ABCB8 Polyclonal Antibody


Rabbit Polyclonal Antibody
Brand: Invitrogen™ PA5120826
Description
Positive test controls include: MCF7, Jurkat, HepG2, HeLa, Mouse heart, Mouse skin, Mouse kidney, Rat heart. The target is usually found in the following locations: Mitochondrion inner membrane, Multi-pass membrane protein. Immunogen sequence: GFEVLKDFTL TLPPGKIVAL VGQSGGGKTT VASLLERFYD PTAGVVMLDG RDLRTLDPSW LRGQVVGFIS QEPVLFGTTI MENIRFGKLE ASDEEVYTAA REANAHEFIT SFPEGYNTVV GERGTTLSGG QKQRLAIARA LIKQPTVLIL DEATSALDAE SERVVQEALD RASAGRTVLV IAHRLSTVRG AHCIVVMADG RVWEAGTHEE LLKKGGLYAE LIRRQALDAP RTAAPPPKKP EGPRSHQHKS.
This nuclear gene encodes a multi-pass membrane protein that is targeted to the mitochondrial inner membrane. The encoded protein is an ATP-dependent transporter that may mediate the passage of organic and inorganic molecules out of the mitochondria. Loss of function of the related gene in mouse results in a disruption of iron homeostasis between the mitochondria and cytosol. Alternative splicing results in multiple transcript variants.
Specifications
| ABCB8 | |
| Polyclonal | |
| Unconjugated | |
| ABCB8 | |
| 4833412N02Rik; AA409895; ABC transporter 8; Abcb8; ATP binding cassette subfamily B member 8; ATP-binding cassette sub-family B member 8, mitochondrial; ATP-binding cassette, subfamily B (MDR/TAP), member 8; ATP-binding cassette, sub-family B (MDR/TAP), member 8; ATP-binding cassette, sub-family B, member 8; EST328128; hypothetical protein LOC548340; MABC1; M-ABC1; mitochondrial ABC protein; mitochondrial ATP-binding cassette 1; mitochondrial potassium channel ATP-binding subunit; mitochondrial sulfonylurea-receptor; MITOSUR; zgc:113037 | |
| Rabbit | |
| Affinity Chromatography | |
| RUO | |
| 11194, 362302, 74610 | |
| -20°C, Avoid Freeze/Thaw Cycles | |
| Liquid |
| ELISA, Immunohistochemistry (Paraffin), Western Blot, Immunocytochemistry | |
| 0.37 mg/mL | |
| PBS with 50% glycerol and 0.02% sodium azide; pH 7.3 | |
| Q5RKI8, Q9CXJ4, Q9NUT2 | |
| ABCB8 | |
| Recombinant Protein (or fragment). | |
| 100 μL | |
| Primary | |
| Human, Mouse, Rat | |
| Antibody | |
| IgG |
Your input is important to us. Please complete this form to provide feedback related to the content on this product.